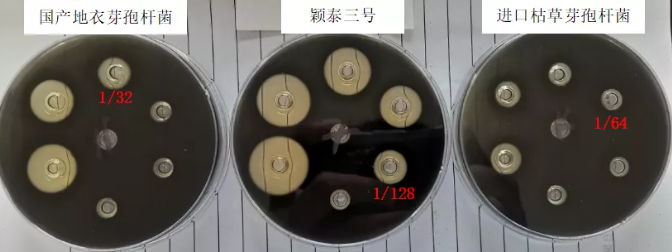
圖片

穎泰三號(hào)主要成分是枯草芽孢桿菌及產(chǎn)生的枯草菌肽抗菌肽,枯草菌肽由37個(gè)氨基酸組成,結(jié)構(gòu)中含有兩個(gè)α-螺旋、一個(gè)連接環(huán)和兩個(gè)二硫鍵。其成分明確,結(jié)構(gòu)清晰,可有效殺滅產(chǎn)氣莢膜梭菌、金黃色葡萄球菌和化膿性鏈球菌等革蘭氏陽(yáng)性菌。
通過(guò)不同方法檢測(cè)穎泰三號(hào)和其他同類芽孢桿菌產(chǎn)品的抑菌性能,評(píng)估不同產(chǎn)品對(duì)產(chǎn)氣莢膜梭菌和金黃色葡萄球菌等革蘭氏陽(yáng)性菌的抑菌效果,為飼料廠在替代抗生素方面的應(yīng)用提供參考依據(jù)。
試驗(yàn)?zāi)康模?/span>
試驗(yàn)方法:參照藥典方法,分別取0.1mL產(chǎn)氣莢膜梭菌CVCC2027、金黃色葡萄球菌CMCC26003細(xì)菌菌液,加入含10mL LB液體培養(yǎng)基的滅菌試管中,再將制備好的3個(gè)待測(cè)樣品溶液分別按照1%、3%、6%的濃度(0.1mL、0.3mL、0.6mL)加入前述試管中。同時(shí)設(shè)立空白對(duì)照(試管內(nèi)只加LB液體培養(yǎng)基和細(xì)菌菌液)。
37℃培養(yǎng),24小時(shí)后測(cè)定各試管菌液OD600nm(用LB培養(yǎng)基調(diào)零),記錄、計(jì)算各產(chǎn)品不同濃度下的抑菌率。
抑菌率=(A空-A樣)/A空*100%
A樣:樣品組24h OD值。
試驗(yàn)結(jié)果如下:


圖1.2 穎泰三號(hào)對(duì)2種細(xì)菌的抑菌效果


圖1.4 進(jìn)口枯草芽孢桿菌對(duì)2種細(xì)菌的抑菌效果
結(jié)論:
試驗(yàn)方法:將3個(gè)樣品益生菌活化,于LB培養(yǎng)基中37℃培養(yǎng)16h,之后將各產(chǎn)品發(fā)酵液離心,取其上清液,用無(wú)菌水2倍梯度稀釋依次制備成1/2、1/4、1/8、……、1/256的樣品溶液,備用。
將各細(xì)菌菌液加入到TSC培養(yǎng)基中,之后倒入放有牛津杯的素瓊脂培養(yǎng)皿中,取出牛津杯,吸取150μL不同濃度的各樣品溶液加入到相應(yīng)的孔內(nèi),同時(shí)設(shè)立滅菌水為空白對(duì)照,并在培養(yǎng)皿上做好標(biāo)記。
將加過(guò)樣的培養(yǎng)皿移入37℃培養(yǎng)箱中培養(yǎng)16h,測(cè)量、記錄抑菌圈。


3種產(chǎn)品對(duì)不同產(chǎn)氣莢膜梭菌的MIC:
表2.2 穎泰三號(hào)和其他芽孢桿菌產(chǎn)品對(duì)5種產(chǎn)氣莢膜梭菌的MIC

圖2.2 不同產(chǎn)品對(duì)豬產(chǎn)氣莢膜梭菌1的抑菌圈

圖2.3 不同產(chǎn)品對(duì)豬產(chǎn)氣莢膜梭菌2的抑菌圈

圖2.4 不同產(chǎn)品對(duì)雞產(chǎn)氣莢膜梭菌1的抑菌圈

圖2.5 不同產(chǎn)品對(duì)雞產(chǎn)氣莢膜梭菌2的抑菌圈
結(jié)論:
注:以上數(shù)據(jù)均來(lái)自農(nóng)業(yè)農(nóng)村部飼用抗生素替代技術(shù)重點(diǎn)實(shí)驗(yàn)室。

撰稿:成鵬、李洪宇

